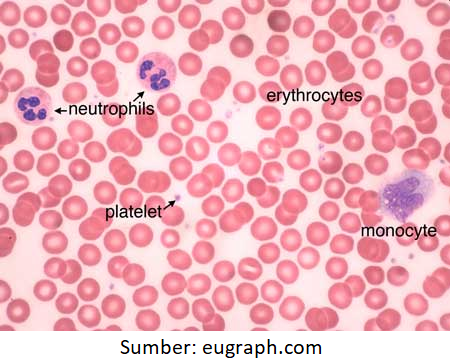

Materi Biologi - Sistem Peredaran Darah Kelas 11 MIA - Belajar Pintar
BelajarPintarV3
Peta Belajar Bersama
Sobat Pintar, sebelum mulai belajar tentang sistem sirkulasi, kita simak dulu peta belajar bersama berikut ini ya....

Struktur Jantung

​​​​​​​
Jantung berada di dalam rongga dada, dibungkus oleh dua lapis selaput perikardium. Di antara kedua lapisan tersebut terdapat cairan yang berfungsi untuk mencegah gesekan permukaan luar jantung dengan organ-organ lainnya karena gerak jantung ketika memompa darah.
Ruang jantung terdiri dari empat ruang yang masing-masing berhubungan dengan pembuluh-pembuluh darah. Terdiri atas dua serambi (atrium) dan dua bilik (ventrikel). Serambi terdiri atas serambi kanan dan kiri (atrium dexter dan atrium sinister), sedangkan pada bilik terdiri atas bilik kanan dan kiri (ventrikel dexter dan ventrikel sinister). Endokardium adalah selaput yang membatasi ruangan pada jantung. Pada serambi kiri terdapat empat muara pembuluh vena pulmonalis yang mengalirkan darah dari paru-paru, pada serambi kanan terdapat dua muara pembuluh vena cava superior yang mengalirkan darah dari tubuh bagian bawah.
Bilik kiri berhubungan dengan satu pembuluh nadi besar (aorta) yang cabang-cabangnya mengalirkan darah ke seluruh bagian tubuh. Bilik kanan berhubungan dengan arteri pulmonalis yang mengalirkan darah ke paru-paru.

Bilik jantung dan bagian-bagiannya
Ruang-ruang jantung sebelah kiri dibatasi oleh sekat pemisah (septum) terhadap ruang-ruang sebelah kanan, tetapi sekat pemisah antara serambi kanan dengan serambi kiri pada fetus masih terdapat lubang yang disebut foramen ovale dan akan tertutup dengan sendirinya kurang lebih 10 hari setelah kelahiran.
Antara serambi kiri dengan bilik kiri dijaga oleh katup berkelopak dua yang disebut katup bikuspid, antara serambi kanan dengan bilik kanan dijaga oleh katup berkelopak tiga yang disebut trikuspid. Katup-katup tersebut diperkuat oleh serat-serat korda tendinae, sehingga katup hanya dapat terbuka ke arah bilik.
Katup-katup lainnya ialah katup semilunar yang berbentuk bulan sabit, yaitu katup antara bilik kiri dengan aorta, serta katup antara bilik kanan dengan arteri pulmonalis.
Dinding jantung terdiri dari otot-otot jantung (miokardium) yang memiliki kemampuan berkontraksi sehingga menjadikan jantung dapat berdenyut. Arteri koronaria merupakan pembuluh darah yang bertugas mensuplai zat-zat makanan dan oksigen sebagai sumber energi otot jantung untuk berkontraksi.
Eritrosit (Sel Darah Merah)

​​​​​​​
Eritrosit disebut juga sebagai sel darah merah. Warna merah pada eritrosit disebabkan oleh adanya hemoglobin. Hemoglobin tersusun dari senyawa besi hemin dan globin (suatu jenis protein).
Peranan utama eritrosit adalah sebagai pengangkut keseimbangan asam-basa cairan darah dan juga mengangkut O2 di dalam tubuh. Setiap molekul hemoglobin (Hb) mengandung 4 atom besi dan setiap atom besi dapat mengangkut 1 molekul oksigen (O2). Molekul-molekul oksigen tersebut diangkut oleh Hb dalam bentuk oksihemoglobin.
Jumlah eritrosit pada seorang pria dewasa sekitar 5.400.000 sel per mm3 dan pada seorang wanita dewasa ± 4.800.000 sel per mm3. Diameter sel-sel ini sekitar 7 mikron dengan ketebalan 2 mikron, sedangkan kadar hemoglobin normal berkisar antara 14 sampai 16 gram per 100 milimeter darah.
Pembentukan eritrosit terjadi di dalam sumsum tulang pipih (tulang belakang) dan tulang pipa. Umur eritrosit rata-rata 120 hari, setelah itu akan dihancurkan di dalam limpa dan hati. Kurang lebih 3 juta sel yang dihancurkan setiap detiknya dan sebanyak itu pula harus dihasilkan eritrosit yang baru. Senyawa hemin dari hemoglobin yang sudah dihancurkan diubah menjadi pigmen empedu berupa biliverdin dan bilirubin. Sebagian besar zat besi dari penghancuran hemoglobin tersebut diangkut kembali ke dalam sumsum tulang untuk pembentukan eritrosit baru.
Preparat smear eritrosit dengan pewarnaan Giemsa
Kelainan Sistem Sirkulasi

​​​​​​Sobat, setelah kalian pelajari komponen dan mekanisme sistem sirkulasi, sekarang lanjut kita pelajari tentang berbagai kelainan pada sistem ini....

Serangan jantung adalah kematian jaringan otot jantung yang disebabkan oleh penyumbatan arteri koroner dalam jangka waktu yang lama. Sementara itu, stroke merupakan kematian jaringan saraf di otak yang disebabkan oleh penyumbatan arteri di otak. Kedua jenis penyakit ini erat kaitannya dengan trombus yang menyumbat arteri.
Trombus terbentuk pada arteri koroner atau arteri dalam otak berupa gumpalan lemak, plak atau jaringan ikat. Gumpalan tersebut kemudian diangkut oleh peredaran darah sampai tersumbat pada arteri yang terlalu kecil untuk dilewati oleh Embolus tersebut. Pada saat ini jaringan di sekitarnya akan mati karena kekurangan oksigen.
Kebanyakan orang menganggap bahwa serangan jantung atau stroke adalah serangan yang tiba-tiba. Padahal kedua penyakit ini merupakan efek final dari kerusakan perlahan-lahan pada sistem peredaran darah. Pada jangka waktu yang lama, gumpalan yang disebut plak mulai menggumpal dan menyempitkan pembuluh darah, disebut juga dengan aterosklerosis.
Faktor yang menyebabkan aterosklerosis antara lain merokok, kegemukan, makanan berlemak, kolesterol tinggi, dan kurang olah raga. Salah satu kolesterol, yaitu LDL (Low Density Protein) menambah jumlah plak dalam pembuluh darah. LDL berbeda dengan HDL yang menurunkan gumpalan kolesterol dalam pembuluh darah.
Materi Biologi SMA - 11 MIA Lainnya
Sistem Pencernaan
5 Sub Bab Materi
Sel
4 Sub Bab Materi
Sistem Gerak
4 Sub Bab Materi
Sistem Pernapasan
4 Sub Bab Materi
Sistem Ekskresi
5 Sub Bab Materi
Sistem Reproduksi
4 Sub Bab Materi
Sistem Imun
3 Sub Bab Materi
Struktur dan Fungsi Jaringan Hewan
5 Sub Bab Materi
Struktur dan Fungsi Jaringan Tumbuhan
3 Sub Bab Materi
Sistem Koordinasi
4 Sub Bab Materi
footer_v3
Bersama Aku Pintar temukan jurusan kuliah yang tepat
sesuai minat dan bakatmu.
Aku Pintar memiliki visi membuat pendidikan merata, mudah dijangkau, dan terjangkau dengan Program Journey Pintar yang merupakan sebuah program persiapan lengkap bagi siswa SMA/SMK/sederajat yang ingin masuk ke perguruan tinggi impiannya.
Kontak Kami
Grand Slipi Tower Lt. 42
Jl. S. Parman Kav 22-24
Jakarta Barat
© 2024 Aku Pintar. All Rights Reserved